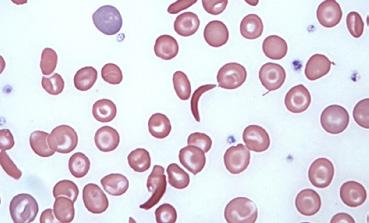

Have
room to explore / an open mind / an argument / an adventure / a point of view / a friend who’s nothing like you / a friend who’s just like you / integrity / a new point of view / a cheesesteak / a mentor / an audience / an impact / a blast


room to explore / an open mind / an argument / an adventure / a point of view / a friend who’s nothing like you / a friend who’s just like you / integrity / a new point of view / a cheesesteak / a mentor / an audience / an impact / a blast


“Trusting our community” and “being transparent” aren’t just things we say to sound nice. In fact, Fords took many of the photographs you will see in this book. This is what our students, professors, and staff experience during the school year. This is Haverford.
“Trusting our community” and “being transparent” aren’t just things we say to sound nice. In fact, Fords took many of the photographs you’ll see in this book. This is what our students experience during the school year. This is Haverford.
4
Haverford attracts ambitious, intellectually curious, independent learners who value honesty, collaboration, integrity, compassion, and, above all, new ways of seeing and improving the world. No place trusts you more to forge your own academic path and contribute so meaningfully to the spirit and fabric of the campus community.
16
30
The unparalleled collegiality between our students and faculty allows you to become a true scholar. Through rigorous academics and an emphasis on hands-on learning (at Haverford everyone does a senior thesis), you’ll engage with your academic work on profoundly deep levels. And in the end, you’ll connect your intellectual and personal growth with ways of changing the world.
As a Haverford student, the world is your campus. Haverford offers state-of-the-art facilities and gorgeous architecture, surrounded by an arboretum with a Nature Trail and a Duck Pond. We are strengthened by our friendly consortium neighbors (Bryn Mawr, Swarthmore, and the University of Pennsylvania) and the resources of Philadelphia, the sixth-largest city in the U.S. And through the Academic Centers and vast study-abroad options, Haverford students experience their education across the globe.
40
When it comes to academics and recreation, we are equally engaged. We participate in more than 145 student-run clubs, make a difference in student government, battle it out during Iron Chef Haverford, spin records at WHRC, and catch flicks during the biweekly film series. We also explore. Philly, a quick train ride away, is our backyard.
52
Haverford’s singular way of preparing you to think and question, to act and assess—to own your learning—builds a framework you’ll use for the rest of your life. Here, with hands-on thesis research, close collegiality with faculty, strong connections via Academic Centers, and engaged support from the Center for Career and Professional Advising, you’ll have everything you need to become an ethical leader in the world.














 Photo: Victoria Merino ‘20
Photo: Lev Greenstein ’20
Photo: Seawon Park ’25
Photo: Cole Sansom ’19
Photo: Arshiya Bhayana ‘22
Photo: Alexandra Iglesia ’21
Photo: Dex Coen Gilbert ’21
Photo: Keyla Ramirez ‘25
Photo: Ella Mbanefo ‘26
Photo: Victoria Merino ‘20
Photo: Lev Greenstein ’20
Photo: Seawon Park ’25
Photo: Cole Sansom ’19
Photo: Arshiya Bhayana ‘22
Photo: Alexandra Iglesia ’21
Photo: Dex Coen Gilbert ’21
Photo: Keyla Ramirez ‘25
Photo: Ella Mbanefo ‘26
Haverford College provides a personal, practical, and challenging education to students from all over the world. Here, on a beautiful campus that came to life nearly two centuries ago, you’ll not only learn: You’ll learn how to learn better, and to do so in a context of ethical engagement with the wider world. You’ll thrive in an open-minded community rooted in trust, concern, and respect. You’ll experience independence, collegiality, and mentorship through distinctive bonds (through frameworks like the Honor Code and Customs). You’ll be transformed personally and intellectually, have more fun than you can imagine, and go out and change the world in your own way.

You’re not coming here to be part of this institution. You’re coming here to define what this institution is.
HARRISON SCHELL
Class of 2016
For a deeper look at Customs, go to: hav.to/customs
Acclimating
to college life can be challenging. The yearlong Customs Program eases the transition through fun social activities and a serious level of peer support.




 Haverford College
Photo: Dex Coen Gilbert ’21
Photo: Jingzhe Jiang ‘25
Photo: Victoria Merino ’20
Photo: Jessica Korgen ‘24
Photo: Alexandra Iglesia ’21
Haverford College
Photo: Dex Coen Gilbert ’21
Photo: Jingzhe Jiang ‘25
Photo: Victoria Merino ’20
Photo: Jessica Korgen ‘24
Photo: Alexandra Iglesia ’21
The collaboration between you, your peers, and the Haverford faculty and staff fosters an empowering environment for everyone. What defines Haverford more than anything else is the trust we place in you to play the central role in your education and in the unfolding of the community experience. At Haverford, the freedom to shape your own path and influence the community and the culture is unparalleled. In and out of the classroom, there is palpable passion, excitement, and joy, knowing we share a commitment to our own individual growth and to working toward something much bigger than ourselves.
700,000
Haverford entrusts Students’ Council with a $700,000 budget annually to fund student clubs and organizations and bring to campus a wide range of speakers, special events, and concerts.



The Honor Code was established in
Haverford’s Quaker roots support socially responsible and intellectually curious
Philadelphia Quakers founded Haverford College in 1833. Although Haverford has no formal religious affiliation today, Quaker ideals strongly influence daily life on campus.
Guiding principles that define a Haverford education include consensus-based decision-making and conflict resolution, openmindedness, critical thinking and questioning, integrity, respect for diverse ideas and backgrounds, and ethical engagement with the Haverford community and the greater world.
Our Honor Code creates an environment that encourages students to work collaboratively and develop into ethical leaders.
Of the many facets that distinguish Haverford, the Honor Code truly sets the College apart. Throughout your time on campus, the common bond created by the Honor Code will enable you to guide your academic affairs, debate the status quo, and support your peers as you all transform as learners and human beings.
Here, you will take self-scheduled exams at home or in unproctored classrooms. You’re trusted to adhere to each instructor’s specific testing rules and regulations. Here, in dorms without RAs, you’re trusted to share living quarters entirely with your peers.
In the social realm of campus life, the Honor Code essentially emphasizes some of the things you probably learned in kindergarten: Treat others as you would wish to be treated, speak your mind, and allow others to be heard.
The Chesick Scholars Program provides a welcoming community and a suite of workshops, seminars, and experiences especially designed for first-generation college students and/or students who come from low-income (FLI) backgrounds. Programming, which begins prior to the start of your first year and extends throughout your time at Haverford, includes expanded faculty mentoring, monthly academic and social gatherings during the school year, and more.
The focus of all Chesick activities is to provide practical guidance for students to achieve their personal, academic, and professional goals as part of a supportive community of fellow students, staff, and faculty. All FLI students are automatically Chesick Scholars, but students can pick and choose to commit to any (or all) of the program’s offerings.
Read more: hav.to/chesick
Classmates and professors with a huge variety of opinions, backgrounds, and world views will make your time at Haverford a very personal and intellectually stimulating experience. We know that a diverse and inclusive community—one that embraces our differences—prepares students to make contributions to the world that are more creative and more profound.
98 of students live on campus

The Class of 2027 hails from
% of students have at least one parent who did not attend college of students speak a language other than English at home 31%
%
Smaller classes open up bigger worlds.
Because we strive to cultivate academic and intellectual discussions rather than deliver rote information, we keep our classes small. This way everyone’s voice can be heard, and everyone’s viewpoint can be respected, weighed, and debated. These intimate, seminar-style classes allow for big discussions, immense exploration, and undivided support, guidance, and attention.
An 8:1 student-faculty ratio means that your professors and academic advisors are almost always available. More than 40 percent of faculty live on-campus and many more live in the surrounding neighborhood, which makes it easy to meet and discuss course work and delve further into ideas.
In fact, some professors even elect to host class at home.
But no matter where the class is held, you’ll seek and discover answers to challenging questions—and you’ll likely continue the conversation over lunch at the Dining Center, over sushi at the Coop, or during a game of Frisbee on Founders Green.
In the end, as a full-fledged Ford, you’ll be equipped with analytical tools and practical experiences that help you sift through knowledge, make smart and efficient decisions, solve problems, and be an agent of change in your field.
96% of students were in the top 10% of their high school class

1,472
Working so closely with faculty produces friendships, mentorships, and remarkably in-depth research.
Classes with fewer than 10 students
Classes with fewer than 20 students
37
71

Professor of Chemistry and Envioronmental Studies
Helen White has been researching the effects of the Deepwater Horizon oil spill for a decade. Haverford students collaborated with White on all aspects of this work, which culminated in the use of some of their research in the litigation against BP, the operator of the well site.
Haverford students genuinely care about this place and the experience that every student has here.
If there’s a barrier to progress, students will lift each other up and over the wall.Class of 2020
Learn more about how you can shape your experience at Haverford: hav.to/sc
At Haverford,
the balance of inclusivity and independence is apparent from the moment you set foot on campus.




 Haverford College
Photo: Keyla Ramirez ‘25
Photo: Jessica Korgen ‘24
Photo: Jessica Korgen ‘24
Haverford College
Photo: Keyla Ramirez ‘25
Photo: Jessica Korgen ‘24
Photo: Jessica Korgen ‘24
Student-run and student-designed programs let you contribute your time and talents to the greater
Whether it’s about the food prepared in Haverford’s kitchens or the topics discussed and explored in your classrooms, you’ll work together with peers, faculty, and staff to serve on administrative committees and challenge one another to drive the campus forward.
In fact, every major decision about running the College—including budgets, hiring, and more— is made with the input of students like you.
• Dorm Olympics
• Supa Fun Dance
• Scavenger Hunt
• Opening Circle

94%
of first-years return for sophomore year. We think it’s because we become so close during Customs.

We’re all in this together.
It all begins with Customs, Haverford’s student-run orientation program, which marks the start of your college life.
Customs Week officially takes place the week prior to the start of classes, but the Customs Program actually stretches throughout your first year. You’ll be greeted by sophomores, juniors, and seniors who are here during Customs Week to help you get your footing. But upperclass students will also live on your hall and help answer questions and connect you with support networks all over campus.
Upperclass students have always fought for these cherished positions, and they’ll make sure you have and know everything you need to make your transition to college life as smooth as possible.
There are more than 70 upperclass students to support nearly 400 first-year students. These student liaisons want to make your acclimation as easy and fun as possible. You can seek their advice when figuring out your course schedule, choosing extracurriculars, and charting your path during your first year.

A student proposed our system of unproctored exams in
Bring your ideas to life.
Becoming an agent of change in your field and all facets of your life demands ambition, dedication, and follow-through. But it also calls for hard-earned experience and the proper tools and training to set your ideas and plans in motion.
Students’ Council receives $25,000 per semester that serves as an innovation incubator for student events. Events are proposed by individuals or by student clubs and organizations. The only criterion is that all events must be open to the whole campus community.
This is how you shape the community.
During Plenary, which happens twice every school year, you’ll gather with peers to raise, discuss, and debate campus issues. The fall gathering focuses on ratifying the Students’ Constitution, while spring centers on approving the Honor Code. For Plenary to occur, a quorum must be reached, meaning that at least two-thirds of the student body must be in attendance. For a resolution to pass, two-thirds of the attending students must consent. The responsibility of carrying out and upholding changes or initiatives falls to the Students’ Council.
Members of ETHOS, Haverford’s ethical-foodadvocacy student group, presented a resolution to shift the school’s Dining Services budget for “food that is ethical, local, ecologically sound, or humane” from 8% to 20%. It was passed by an overwhelming majority, and the resolution’s terms were fully realized 10 months ahead of schedule.

Students’ Council members offer advising and financial backing, as you take the lead in planning and executing your event.
Whether you’re planning a campus-wide celebration, a cultural experience, or an educational lecture or workshop, this funding will give you an opportunity to bring your ideas to life for the campus community and increase your experience with organizing and executing your vision.

As you perform real-world research and immerse yourself in our rigorous curriculum, you’ll work closely with professors who double as colleagues and mentors. This collaborative spirit cultivates independent thinking and fosters the pursuit and creation of knowledge—leading you to examine issues and discover answers to questions you didn’t know existed.

At Haverford and throughout the process of my thesis,
I definitely grew the creative, imaginative parts of my person that I want to keep growing.
Read more about where our students go after graduation at the Where They’re Headed section of haver.blog
Your education at Haverford is a partnership between you, your peers, and your professors—leaders in their fields who help you shape your distinct intellectual path.




 Haverford College
Professor Suzanne Amador Kane
Photo: Sumita Lacey ‘26
Photo: Jessica Korgen ‘24
Photo: Ella Mbanefo ‘26
Photo: Jessica Korgen ‘24
Haverford College
Professor Suzanne Amador Kane
Photo: Sumita Lacey ‘26
Photo: Jessica Korgen ‘24
Photo: Ella Mbanefo ‘26
Photo: Jessica Korgen ‘24
Haverford’s three Academic Centers provide opportunities for students and faculty to enrich their scholarship beyond the classroom. In addition to hosting influential speakers, events, and symposia, the Centers are your primary funding source for internships and externships.
As grant-making entities to some 150 students per year, the Centers open channels across all disciplines, uniting you with faculty to test hypotheses in the arts, science, and social sciences. With global reach, each Center offers comprehensive resources and tools, along with support to help you design your own high-level scholarship and make connections with experts and organizations around the world who are doing transformative work.
The Center for Peace and Global Citizenship (CPGC) embodies Haverford’s commitment to the study and promotion of social justice across all academic disciplines.
Through the CPGC, you can develop project proposals to attend conferences, do deeper senior thesis research, or influence campus conversations by bringing speakers or symposia to campus. And the summer internship program allows students to integrate scholarly learning with practical experience, sending students across the globe on self-designed projects.
students receive CPGC Summer Fellowships annually, enabling funded internship experiences in the U.S. and around the world. Some examples include:
Ardmore Victory Gardens (Philadelphia, PA)
Taylor DiFilippo ’25
Voice of Witness (San Francisco, CA)
Lily Aparin-Buck ’25
Nearly
20%
of students participate in financially-supported international and domestic experiential learning through the CPGC

Reusable Pads Nepal (Nepal, Asia)
Kripa Khatiwada ’26
Child Family Health International Global Health in South Africa (Cape Town, Africa)
Nathan Ma ’24
The heart of natural science research at Haverford, the 188,000-square-foot Koshland Integrated Natural Sciences Center (KINSC) houses the Departments of Astronomy, Biology, Chemistry, Computer Science, Mathematics, Physics, and Psychology. But it’s more than just a building: The KINSC is one of Haverford’s three Academic Centers as well.
The Center catalyzes and facilitates programs that maintain Haverford’s position at the leading edge of academic excellence in the sciences. Here, the faculty, staff, and students share instruments, methodologies, and expertise across disciplines in collaborative research and investigation. From NMR machines and electron microscopes to ultracentrifuges and telescopes, the KINSC houses everything you need to develop as a scientist.
The KINSC also provides stipends to both students and faculty for summer research and scholarship, including projects abroad. Other opportunities include funding for students to attend conferences and workshops, and sponsorships for seminars and scholarly projects, many of which involve students and faculty from multiple departments.
Each fall, the Center hosts a research symposium that showcases student work from Haverford, Bryn Mawr, Swarthmore, and other area colleges. Throughout the year, speakers from around the world also come to share their findings, insights, and experiences.

THE STRAWBRIDGE OBSERVATORY houses 12- and 16-inch telescopes used by students and the public to study the stars and explore the heavens.
$10,000 STUDENTS CAN RECEIVE UP TO IN RESEARCH FUNDING THROUGH THE ACADEMIC CENTERS
The John B. Hurford ’60 Center for the Arts and Humanities (HCAH) connects our campus with the writers, artists, performers, thinkers, activists, and innovators of today and generations past. Located in the Visual Culture, Arts + Media (VCAM) facility, HCAH has exhibition spaces that double as active classrooms and present diverse art and ideas drawn from multiple disciplines that will challenge and enrich the way you see the world.
As a researcher in the humanities, you have multiple opportunities to work with the HCAH, which provides stipends, summer research assistantships, and internships. The HCAH also provides funding to support original student art projects, exhibitions, and theater performances.
The Hurford Center sponsors reading groups, so you can study literary texts outside the formal classroom environment. It also funds small, not-forcredit, student-run seminars on myriad creative, boundary-stretching topics such as “Technologies of Control: Surveillance and Socialization in Total Institutions and Broader Society,” and “The Writing on the Wall: Graffiti, Street Art, and a New Organic Urban Architecture.”
The HCAH works with the Cantor Fitzgerald Gallery—a classroom, workshop, laboratory, and exhibition space all in one—to partner with faculty, students, and visiting curators to create works that connect curricular interests and scholarship with contemporary artistic practice.

Recent Exhibits
Seeing Sound
Curated by Barbara London
Extra Medium | John Muse
Curated by Homay King
Let’s Get Free: The Transformative Art and Activism of the People’s Paper Co-op
Curated by Raquel de Anda, Sharita Towne, and Daniel Tucker
When it comes to making the most of college, some students set themselves on specific careers from the jump, while others take paths they’d never dreamed of. No matter which camp you’re in, when you settle into life at Haverford, we’re here to always make it easy to ask questions, get answers, focus on the tasks at hand, take chances, and evolve as a student and citizen of the world.

The OAR is committed to strengthening student learning, persistence, and scholarship, and advancing the teaching and learning mission of the College. We seek to be a center where knowledge is generated for transformative purposes, both at individual and institutional levels.
The rigor of Haverford presents new demands and expectations on how you learn from intentionally designed, challenging forms of instruction; therefore, academic success at Haverford requires adoption, acquisition, and/or adjustment of new habits, skills, and practices to help you reach your goals. The OAR is an unlimited (free) resource available anytime from Customs to Commencement, to help you—or your class, team, or peer group—reflect, plan, and strategize on how to make your academic journey at Haverford more meaningful and impactful.
We achieve this through academic support structures at the professional and peer levels. We work closely with faculty to provide peer-led, content-level learning support for all
In an academic year, the OAR schedules:
3,000 hours of peer tutoring
First-years and sophomores make
77% of all TUTORING APPOINTMENTS and
introductory STEM and language courses. The ultimate goal is to provide you with the ability to master, outside the classroom, the skills and competencies necessary to thrive academically in your courses.
We also provide peer and professional academic coaching. Coaching is a collaborative and empowering resource for any student who wants to be a better learner, a lifelong endeavor. Coaching can help you manage your time, manage large projects, learn scholarly reading practices, and develop disciplinary-specific ways of knowing and doing, among other things.
The OAR recognizes that every Haverford student has a unique story, and we lean into your story to identify your strengths to help you create goals, reflect on progress, and overcome challenges (which are normal for growth).
We believe all students can be successful at Haverford, however you define success; we’re here to walk with you every step of the way, during any part of your journey.
Our libraries are sanctuaries for studying and buzzing hives of research.
With exceptional collections, rare titles, and art and artifacts, along with the latest research tools, our library system exists and evolves to develop your academic excellence and personal growth through a liberal arts education.

Haverford’s main library, Lutnick, serves a campus that also includes four smaller specialized libraries: the Astronomy Library, the Gilbert F. White Science Library, the Music Library, and the Cricket Library, which documents the intertwined history of the sport and Haverford College itself.
Inside Lutnick Library, you’ll have access to more than half a million volumes in the form of printed books, microfilm, photographs, diaries, letters, sound and video recordings, electronic publications, and miscellaneous ephemera. In addition, a catalog system that connects to libraries at Bryn Mawr and Swarthmore gives you access to 2.5 million additional volumes. The renovated library building features beautiful lightfilled spaces, a café, classrooms, a screening room, galleries, a conservation lab, and more.
The main library houses:
500,000 TITLES
2 COPIES of the John James Audubon elephant folio printing of The Quadrupeds of North America
1st editions of works by Newton, Einstein, Darwin, Copernicus, and Cervantes
When it really comes down to it, everyone’s a “creative.”
Artistic expression and appreciation lead to new viewpoints—viewpoints that you’ll find yourself applying to your life inside and outside your classes and laboratories. Even if you don’t take a class in the arts, our wide array of student-generated programming, clubs, and exhibitions will ensure that you see the world in a new light.
Arts Programs at Haverford
Creative Writing / Drawing / Music Theory / Music Composition / Music Performance / Musicology / Painting / Printmaking / Photography / Sculpture / Visual Studies
Arts Programs at Bryn Mawr Theater / Dance
The Visual Culture, Arts + Media (VCAM) facility provides 3-D printing, prototyping, fabrication, and other leading-edge resources for film and digital media-making, curatorial experimentation, and arts exhibition design. It is also home to the John B. Hurford ’60 Center for the Arts and Humanities.

45+
arts-related clubs, including Lighted Fools, a sketch comedy and improv troupe
I’ve been in multiple classes now where I feel like my life was actually changed —
I learned things of fundamental personal importance, and the professor was not only willing to talk me through it, they were invested in my learning and my process even after the semester was over.
Read about some of the interesting, unusual, and unique courses that enrich the Haverford College experience in the Cool Classes series at: haver.blog
Knecht has taken a few classes featured in the “Cool Classes” series, such as “John Brown’s Body,” an English course that uses the spectacular life and death of John Brown to examine issues such as the place of violence in the cause of liberty, the shifting terrain of civil disobedience and terrorism, and the roles of race and gender in the construction of emancipatory rhetoric.




 Haverford College
Miles Knecht ’19
Photo: Alexandra Iglesia ’21
Photo: Alexandra Iglesia ’21
Photo: Lev Greenstein ’20
Haverford College
Miles Knecht ’19
Photo: Alexandra Iglesia ’21
Photo: Alexandra Iglesia ’21
Photo: Lev Greenstein ’20
Every student completes a senior thesis here. As the culmination of your academic experience, this is your opportunity to do original, independent research in partnership with faculty members, at levels usually reserved for graduate students.
We’re one of very few institutions in the U.S. that include such a challenging research project as part of every student’s academic program. As you work toward proving your hypothesis, you’ll use state-of-the-art tools and resources and tap into the worldwide Haverford network.
In the end, you’ll understand (at a level unfamiliar to the great majority of traditional college graduates) what it takes to create knowledge and seek answers to challenging questions. And it’s quite possible that you’ll graduate having designed and completed a project that could become the foundation for future research fellowships, career paths, or lifelong pursuits.
You’ll have assistance beyond your faculty mentor. At the Office of Academic Resources (OAR), our libraries, and our Academic Centers, all manner of resources, coaches, guides, and counselors await to help you bring your senior thesis to life.

Recent Senior Theses
Optimizing MLB Free Agency With the Genetic Algorithm
Subject to Reform: Race, Caste, and the Gendered Governance of Female Sexuality in Late Colonial India (1887–1929)
Investigating the Link Between Alzheimer’s Disease and Sleep Deprivation
Examining the Failure to Care: Shaming as a Public Health Strategy During and Beyond the Coronavirus Pandemic
Investigating the Role of Helix III Mutation in Acyl Carrier Protein Conformational Dynamics and Protein Binding in Type II Fatty Acid Biosynthesis
Read about the results of students’ theses on the What They Learned section of haver.blog

The ocean can be your laboratory.
Thanks to a partnership between the Center for Peace and Global Citizenship and the Koshland Integrated Natural Sciences Center, students from Kristen Whalen’s “Advanced Topics in Biology of Marine Life” class spent a week over winter break exploring tropical coral ecosystems in Roatán, Honduras. Students went snorkeling twice per day to explore coral diversity and identify fish, turtles, invertebrates, and algae on the second largest coral reef on Earth, known as the Mesoamerican Barrier Reef.
Read about their trip at hav.to/kwr
Your senior thesis can launch your career.
George P. Smith ’63 is the fourth Haverford alumnus to win the Nobel Prize. A biology major while at Haverford, he credits his thesis advisor with introducing him to molecular immunology which shaped his early career. Smith was honored with the Nobel in Chemistry for his work developing phage display, which uses bacteriophages – viruses that infect bacteria – to evolve new proteins. This “elegant method” (as the Nobel officials described it) eventually contributed to new drugs and antibodies that treat metastatic cancer, autoimmune diseases, and more.
You’ll be guided throughout your senior thesis by a faculty mentor.
Students work closely with their mentors and often find them early in their studies. Opportunities for research are available as early as your first year at Haverford.


Choosing a major is a milestone decision, but it shouldn’t be so weighty that it stops you in your tracks. Most students don’t know exactly what discipline to zero in on until they start taking classes, talk with their peers and professors, and understand the subjects and ideas that inspire them a little more clearly.
Here, our closely knit campus, outgoing student body, connected faculty, and great number of classes make it easier to explore your options.

Working together yields the deepest learning and greatest growth.
Thanks to collaboration between the students, faculty, and staff within the Tri-College Consortium, the depth and breadth of your Haverford education are second to none. And thanks to significant social interaction among all the schools of the Consortium, you’ll be exposed to an even wider variety of experiences, wisdom, and points of view—whatever major you choose.
People often assume that research is this solitary practice, but I work with four or five students each year, and we’re really actively collaborating every day.
SUZANNE AMADOR KANE, PROFESSOR OF PHYSICS AND ASTRONOMY734
As a Haverford student, you can choose from more than classes
2,200
offered by the schools in the Tri-College Consortium: Haverford, Bryn Mawr, and Swarthmore.
61% of students have at least one MINOR or CONCENTRATION

Fast-track your master’s degree.
Haverford works with five institutions to offer accelerated-degree partnership programs, so you can get a head start on your master’s degree.
• 4+1 Bioethics Program, Accelerated Masters Program in Engineering, and 3/2 City and Regional Planning Program (University of Pennsylvania)
• 3/2 Engineering Program (California Institute of Technology)
• One-year Master’s program (Robert Day School of Economics and Finance at Claremont McKenna College)
• Five-year program with the Center for Latin American Studies (Georgetown University)
• Two-year China Studies Master’s program (Zhejiang University)
11 Areas of Concentration
Africana Studies
Biochemistry
Biophysics
Creative Writing
Education & Educational Studies
Gender & Sexuality Studies
Latin American, Iberian & Latinx Studies
Mathematical Economics
Middle Eastern & Islamic Studies
Peace, Justice & Human Rights
Scientific Computing
Applied Math
Anthropology
Asian American Studies
Astronomy
Chemistry
Chinese Classics
Comparative Literature
Economics
Education & Educational Studies
Environmental Studies
Fine
French
Gender & Sexuality Studies
German
Greek
Anthropology
Archaeology
Astronomy
Astrophysics
Biology
Chemistry
Chemistry (ACS-certified)
Classical Culture & Society
Classical Languages
Comparative Literature
Computer Science
Dance
East Asian Languages & Cultures
Economics
English
Environmental Studies
Fine Arts
French & Francophone Studies
Geology
German & Germanic Studies
Greek Growth & Structure of Cities History
History of Art
Romance
Spanish Theater
17% of Fords graduate with more than one major
Haverford’s location offers the best of all worlds: a serene yet dynamic campus, close proximity to our extraordinary consortium partners, and a site nestled within one of America’s greatest metropolitan areas. All of this dramatically increases the scope of your education without sacrificing the quintessential small-college experience. Here, you’ll encounter a vast array of events and programming, along with world-class resources, culture, and history; you’ll also have life-changing, hands-on learning experiences throughout the region and the world. As a Haverford student, you will truly engage with the world around you—near and far.

I’m from a small town, so the opportunity to hitch a ride on a local train and be right in the thick of things is something I really appreciate.
Experience Philadelphia and engage with the city. The Tri-Co Philly Program is a semester-long program that provides students both curricular and co-curricular activities in Philadelphia: hav.to/tcp
The city of Philadelphia dramatically expands the size of our campus and deepens
the impact of your college experience.




 Haverford College
Photo: Alexandra Iglesia ’21
Photo: Claire Blood-Cheney ’20
Caroline Tien ’20 and Maya Ahmed ’20
Photo: Alexandra Iglesia ’21
Haverford College
Photo: Alexandra Iglesia ’21
Photo: Claire Blood-Cheney ’20
Caroline Tien ’20 and Maya Ahmed ’20
Photo: Alexandra Iglesia ’21
Explore a historic region, forge your future, and have a lot of fun along the way.
Our beautiful arboretum campus provides an extraordinary setting for living and learning together, but in addition to the community you’re creating here, you have access to a major city, just eight miles away, that can be used as a playground for you to develop your interests and professional aspirations. Students use Philadelphia as a laboratory to explore urban landscapes, policy, education, history, art, and more with their professors and classmates, or as a site of professional training, interning at one of the city’s Fortune 500 companies or major cultural institutions. Having a vibrant cultural epicenter so close by creates incredible opportunities to apply what you learn in your classrooms and labs, and draw inspiration in the form of films, music, art, sports, and nature.

Conduct high-level research on— and way off—campus.

Philadelphia is as rich with arts and cultural resources as it is with volunteer, internship, and job opportunities
Philly is the first
in the U.S. (cited for its blend of rich history and contemporary culture)
more outdoor sculptures and murals than any other American city
We at the College recognize that we live and work on Lenape land, and pay respect and honor to the caretakers of this land, from the time of its first human inhabitants until now, and into the future.
Haverford’s reach extends throughout the region, country, and world. With funding from our Academic Centers and other resources, you can spend semesters and summers abroad or engage in shorter trips to conduct research. Travel funding is available for attending professional conferences, taking part in symposia, working off campus in conjunction with professors, and doing national and international internships and externships.
These kinds of opportunities expose you to information, resources, facilities, and experiences that will deepen your scholarly work, inspire you as you complete your senior thesis, and profoundly expand your world. tree-tostudent ratio 6:1
• Population: 1,603,797
• Founded: 1682, by Quaker leader William Penn
• B irthplace of American independence
• 6th-largest city in the U.S.

Tap into a region flowing with opportunities.
The vibrant urban region all around Haverford’s campus is as rich with arts and cultural resources as it is with service and employment opportunities. As a Ford, you’re less than 30 minutes by train to Center City Philadelphia, where you can access all of the opportunities and resources of a huge metropolis.
The Main Line will take you there.
Haverford is located on the Main Line, a regional rail line and series of communities with roots in William Penn’s day. All it takes is a 10-minute walk from campus, and you’re on the train and on your way to Philadelphia. Public buses and trolleys are also available to transport you hassle-free to Philly for research or internship and volunteer work— or to one of the city’s six universities.
Throughout the school year and summer, you can enrich your education (and daily life) with forays throughout Philadelphia and the surrounding neighborhoods to explore, take classes through the Tri-College Consortium, do internships, shadow mentors, and work.

To get to Bryn Mawr, just hop on the free Blue Bus, which runs between campuses every day (and into the night on Fridays and Saturdays). To get to Swarthmore, catch a shuttle that runs between all three campuses daily.
Delight in the dynamic communities surrounding campus.
Haverford—in a neighborhood that’s loaded with great shops, cafés, and restaurants—is halfway between Ardmore and Bryn Mawr.
In the Ardmore neighborhood, you’ll find Suburban Square, an outdoor mall with both big-name brands and little boutiques. If you’re hungry there are tons of restaurants to choose from, or if you want to whip something up back at your campus apartment, you can pick up provisions at Trader Joe’s or the Ardmore Farmers’ Market. In Bryn Mawr, see an indie film at the Bryn Mawr Film Institute and peruse the racks at Showcase Comics and Games. Hungry? Great Mexican, Indian, Vietnamese, Japanese, and Italian food awaits you.
Studying abroad in London was one of my major highlights of college. Not only was I able to take courses not offered at Haverford, but also it motivated my joint thesis in computer science and math. I walked hundreds of miles, took thousands of pictures, and experienced countless memories—
Check out the Haverford Study Abroad Office Instagram as student traveler-researchers share stunning snapchats of their treks: hav.to/saphotos
About
35 percent of our students spend a semester or more learning outside the United States.





Studying abroad expands your world by instilling in you an immeasurable sense of confidence. Take it from these Fords, who immersed themselves in the classrooms and cultures of countries previously foreign to them.
35% of our students STUDY ABROAD




My study abroad experience in Iceland taught me so much more than I could’ve imagined.
I adventured, restored, recentered myself, and made lifelong friends. The experiential learning component of my program cemented my desire to study and work in climate change and renewable energy, and the people I met opened my horizons to new ways of engaging with that work.
EVA WHITE ’23 Physics major, Ísafjördur

Whether it’s doing cuttingedge fieldwork in Brazil, playing music near the Danube, or studying Japanese with a view of Mount Fuji — our faculty, staff, and Academic Centers will support you in your efforts to apply what you learn in the classroom to the real world.
When reflecting on my time in Ireland, the feeling that comes to mind is joy—
not only because the Irish are perhaps the most welcoming, boisterous folks to walk the earth, but because, through a rollercoaster of learning experiences (both in the classroom and on the streets of Dublin), I found confidence in myself. Living abroad reminded me that I am capable of working through challenges, and at the same time, it showed me that I can create great things for myself.
CALAIS IRWIN ’23 Political Science major, Dublin
IN ANY HAVERFORD-APPROVED study-abroad program,

A vivid sense of community is the heart of life at Haverford. It starts during the first week of Customs, and deepens naturally as your friendships and mentorships develop over the years. Of course, these bonds are built inside our classrooms, labs, and studios, and they grow even stronger on the outside. When we aren’t investigating or creating knowledge, we’re influencing student government, letting off steam on the playing fields, and sharing meals in our cafés. Every week, every weekend, there’s a chance to do something you love or something brand new.

Fords put as much energy, enthusiasm, and thought into their recreation as they do their studies. Here, you have tons of opportunities to play, have fun, and explore.
Living alongside so many of your peers, you’ll find it’s easy to make friends, build on shared interests, and get the most from an existing club or the one you start. And living near one of America’s greatest cities vastly increases your options for making the most of your undergraduate years.

Activate all of your senses.
There’s always something to do, see, and hear on campus, thanks to Students’ Council and the Student Activities Office. These two organizations distribute $700,000 to fund cool oncampus events such as concerts by national bands, board game nights, and food truck fests, plus Philly field trips and landmark tours.
And beyond that, our close consortium ties to Bryn Mawr and Swarthmore grant you access to everything on their entertainment and recreational dockets as well.

The best things in life are free. Haverford hosts a huge array of events on campus, and the best part? All events are free to students. That includes concerts, performances, lectures, author events, film premieres, and more!
TRI-COLLEGE (TRI-CO) CONSORTIUM EVENTS
• Catch a flick during the annual Tri-Co Film Festival.
• Collaborate and code with fellow techies during the Tri-Co Hackathon.

As the academic year draws to a close, there’s no better way to celebrate than Haverfest.
If flowers are blooming and the mercury’s rising, that means it’s Haverfest time. The spring tradition always draws great DJs and bands to Founders Green, where students throughout the consortium turn the arboretum from calm to clamorous.


Haverford’s WHRC, one of the world’s first college radio stations, began broadcasting in 1923. Today, the web-based audio collective provides an eclectic soundtrack for Fords and listeners around the world. Tune in to hear (or post) enlightening record reviews, catch community news, and express yourself through podcasts, music shows, and multimedia projects.

Goodbye, winter. Hello, pinwheels.
When it comes to the official start of spring, some people consult calendars and stars, while others wait for shadows cast by a certain Keystone State groundhog. At Haverford, the season doesn’t officially arrive until campus awakens one morning to a cheery field of colorful, spinning pinwheels on Founders Green. This is Pinwheel Day—our annual celebration of warmer weather’s return.
As a Ford, in addition to serving on faculty hiring committees, managing the student activities budget, and scheduling your own exams, you can help guide any of the more than 145 campus clubs and organizations.
You’re sure to find yourself integrating and applying what you experience and learn throughout your undergraduate life and beyond.

Fords Against Boredom (FAB) makes sure the fun never stops.
Throughout the history of Haverford, students have founded many clubs that have contributed greatly to the vibe and culture of campus.
But since 1993, there’s been just one student-run group that’s helped Fords bond through Iron Chef-style cooking competitions, traditions anchored by comfort food, and five-star Philly field trips. That club is Fords Against Boredom, better known as FAB ... because it is.
Look to FAB for Quizzo and Casino Nights and Ben & Jerry’s Bingo, plus finals week cheesesteak runs and Midnight Breakfast (when deans and the President serve students tater tots and bacon).
All year, the group ensures that there’s always something fun and free for everyone to do on campus—and in Philadelphia, where FAB outings include visits to museums, concerts, theaters, and sporting events.

clubs and organizations
Here’s a sampling:
Best Buddies
Black Student League
Charcuterie Union
Diabesties
Federation United Concert Series
Fiber Arts
Haverford Outdoors Club
Haverford Robotics
Haverford Quiz Bowl Team
Literary House
Nerd House
The Outskirts
Sound Machine
Street Outreach
Women in STEM
I joined FAB during my sophomore year because I love planning events. I especially love organizing events like Watertag, Ben and Jerry’s Bingo, and Screwdate because they help to build community on campus.
MAY COURTNEY ‘24
And don’t forget about Philly ...
The HaverTicket is your means to witnessing and getting involved in all sorts of regional action. Through the Student Activities Office, you can secure HaverTickets (subsidized travel tickets, tokens, and passes) to use SEPTA, the Southeastern Pennsylvania Transportation Authority.
The Schuylkill River Trail and Schuylkill Banks Boardwalk
Following the path of the Schuylkill River are more than 60 miles of trails to walk, run, and bicycle. The Schuylkill Banks Boardwalk is the place to catch cool nighttime views of the downtown skyline.
While a slice at Lorenzo’s, a cannoli at Sarcone’s or a cheesesteak at Pat’s or Geno’s will set you back a few bucks, a walk up and down the historic curbside market hasn’t cost a thing since the place got going in the late 1800s.
Independence National Historical Park
Pay homage to the birthplace of American democracy inside America’s most historic square mile.
Philadelphia Museum of Art
Pay what you wish”—finer words are never spoken when you’re on a college student’s budget. Be there on Friday evenings or the First Sunday of every month to take in a masterwork for nothing (or next to it).
Philadelphia Orchestra’s Free College Concert Night
Every year, a free concert just for college students kicks off The Philadelphia Orchestra’s eZseatU program, which brings thousands of students to Verizon Hall to experience the famous Philadelphia Sound.
Have fun and play games
Around the Boardwalk at Spruce Street Harbor, there are tons of games to play like bocce, shuffleboard, and Ping-Pong. There are also Ping-Pong tables and corn hole games that are available to play for free at Love Park all year around!
Tunes and Reads
Philadelphia is jammed with A-plus bookshops and record stores. Here are two with free, second-to-none ambiance: Brickbat Books (Fabric Row at 4th and South) and Long in the Tooth Records (20th and Sansom).

First Library
First Hospital
First Medical School
First Capital
First Zoo
First Stock Exchange
First Business School
Philly’s 6
• NHL Flyers
• NBA 76ers
• MLB Phillies
• NFL Eagles
• MLS Union
• NLL Wings
Train times from Philly to 1.5 hours
Ice-skate at Penn’s Landing or rollerskate at City Hall. Rock out at the Fillmore. Take in a special exhibit at the Museum of Art. Track the puck at a Flyers game. Shop the Punk Rock Flea Market.

FIRST-YEAR AND UPPER-CLASS STUDENT RESIDENCES
Barclay Hall
Gummere Hall
Jones Hall
Tritton Hall
Now, this is living.
As a first-year Ford, you’ll live with your Customs Group of 8 to 16 people in one of four safe, comfortable, and environmentally friendly first-year residences.
UPPER-CLASS STUDENT RESIDENCES
Comfort Hall
Haverford College Apartments
Kim Hall
Leeds Hall
Lloyd Hall
Lunt Hall
SPECIAL-INTEREST HOUSES (UPPER-CLASS STUDENTS)
Cadbury House
Ira de A. Reid House
Latinx Cultural Center
Literary House
Nerd House
PANAHouse
QHouse
Quaker House

As for the most important part of residence hall life—decorating your room and the hall itself— well, we leave it entirely up to you. For inspiration, check out the dorm tours in our Instagram reels.
Let’s make a match.
Each clean and spacious coed residence offers a wide variety of accommodations, including double and single rooms, suites (groupings of single rooms that share a lounge), and apartmentstyle housing with kitchens and private bathrooms. Also, each building has its own distinct vibe, history, and environment. Through housing questionnaires, we’ll pair you with the place that best suits your disposition, interests, needs, tastes, and goals.
Whether at a main meal, late-night study break, or spur-of-the-moment meetup, you’ll find delicious, healthy, sustainable food to fuel your interactions.
In the Dining Center, a.k.a. the DC, there are always fantastic vegetarian options, plus fresh fruits and vegetables, made-from-scratch desserts, and locally sourced dairy and bread (local produce and meat, too, when available). There’s a vegan bar and a gluten-free room, as well as specialty stations like the omelet bar, pasta bar, and stir-fry station.


Haverfarm’s fresh approach enhances campus cuisine.
Haverford’s student-run club and farm, Haverfarm, ensures that your plate is rounded out with sustainable sustenance that’s traveled only a few yards from the field to your table. Working across four plots spread around campus, Haverfarm student-workers deliver carrots, rhubarb, and other just-picked produce to the DC every week (when in season, naturally).
At the Coop, which also benefits from Haverfarm’s bounty, you can dig into a variety of hot and cold lunch items: pizza, salads, soups, sandwiches, beverages, yogurt, snacks, and desserts.
Every now and then, of course, you’ll want to go “off menu” and seek out the stuff you can’t get on campus. There are plenty of restaurants nearby, and most of them deliver to campus, so whatever you’re craving isn’t far away.

The Haverfarm is a year-round farming and educational space designed to integrate sustainable food and agriculture into the academic and extracurricular lives of Haverford students, faculty, staff, and community members.
With a focus on interdisciplinary and experiential learning, the Haverfarm invites students and other members of the community to engage with issues of food justice and local, progressive agriculture. Produce is distributed to students, community members, the Dining Center, and local food banks.
To me, receiving a quality education isn’t solely dependent on academic courses, and
I wanted to make the most of my collegiate experience.
Class of 2021
Learn more about Haverford’s scholar-athletes: hav.to/studentathletes
For students like Jesse Turkson, who majored in economics, participated in the Black Students League, and started for the basketball team, Haverford’s balanced approach to learning and extracurriculars, as well as the sense of community in and out of the classroom, was the ideal fit.




 Haverford College
Photo: Rae Yuan ‘19
Photo: Arshiya Bhayana ‘22
Jesse Turkson ’21
Photo: Alexandra Iglesia ’21
Photo: Arshiya Bhayana ‘22
Haverford College
Photo: Rae Yuan ‘19
Photo: Arshiya Bhayana ‘22
Jesse Turkson ’21
Photo: Alexandra Iglesia ’21
Photo: Arshiya Bhayana ‘22
Ever since campus planner William Carvill organized the first cricket squad at Haverford in 1834, athletics have played an essential role at Haverford.
Whether you’re an elite varsity runner competing in a conference championship or a flag football enthusiast darting around Cope Field, exercising the body and mind go hand-in-hand at Haverford. Athletics allows students to grow and learn, express creativity and leadership, and strive for excellence just as they do in the classroom, in the laboratory, or on stage.
At Haverford, you can compete and challenge yourself at the highest level without sacrificing your identity as a student, scholar, and full community member.


We’re Fords. So what’s with the Black Squirrel?
Haverford competes in the NCAA Division III’s highly competitive Centennial Conference. We’re cheered on by our mascot, the Black Squirrel, whose real-life cousins are longtime denizens of our arboretum campus and a symbol of feisty, energetic determination.

WE FIELD THE ONLY
• Rhodes Scholar Andrew Lanham ’10 (cross-country team captain)
• Nobel Prize winner Joe Taylor ’63 (soccer standout)
• Former University of Iowa and Cornell president Hunter Rawlings ’66 (basketball league MVP)
Haverford’s baseball presence? Big league: hav.to/mlb
of our students are on varsity or club teams

Our weight rooms, tracks, fields, and gyms go the distance.
Our workout facilities are equipped with all of the tools and resources you need to build stamina, speed, strength, skill, and spirit—no matter your sport or discipline.
• The Douglas B. Gardner ’83 Integrated Athletic Center (known as the GIAC) is a contemporary, eco-friendly, 100,000-squarefoot complex geared toward all things exercise, training, and fitness. It also houses the Calvin Gooding ’84 Arena—home of the men’s and women’s basketball teams.
• Built in the 1950s, the historic 58,000-square-foot Alumni Fieldhouse has been retrofitted and features state-of-the-art surfaces for tennis matches and all indoor track and field events.
• In addition to the immaculate Swan Field, our outdoor practice and playing fields include an all-weather 400-meter track, the Alumni Cross Country Course, and eight additional excellent turf fields for cricket, softball, baseball, soccer, and more.
The opportunity to manage your own learning, collaborate with faculty, and connect knowledge across disciplines builds a framework that you’ll use forever. Whether you’re destined for graduate or medical school, entrepreneurship or the arts, the business or banking realms, or elsewhere in the world at large, you’ll always find yourself applying the unique academic and social skills you cultivate at Haverford. Here’s how Haverford graduates are enriching daily life, working toward grand cures for society’s ills, and, in general, improving the world.
 Haverford College
Haverford College
For me, Haverford has been a perfect fit because of its commitment to student agency, and
to developing these relationships between students and professors that I think are pretty unique to this college.
Class of 2023
One of four Fords awarded the prestigious Fulbright scholarship in 2023, history major Rhea Chandran will use the nine-month grant to build upon her senior thesis research, which delved into the history of the prostitution industry in India, where it is rooted in the caste system of the country’s pre-colonial past. With funding from the history department, Chandran carried out archival research for her thesis in the India Office archives in London; the Fulbright facilitates an expansion of that research to include archives in India, with a focus on modern women.




 Learn more about Chandran’s senior thesis and Fulbright scholarship: hav.to/rc23
Haverford College
Becca Matson ’22
John Jayasankar ‘22
Leo Gruenstein ’25
Rhea Chandran ’23
Maria Reyes Pacheco ’24
Learn more about Chandran’s senior thesis and Fulbright scholarship: hav.to/rc23
Haverford College
Becca Matson ’22
John Jayasankar ‘22
Leo Gruenstein ’25
Rhea Chandran ’23
Maria Reyes Pacheco ’24
A Haverford education carries clout worldwide. Here’s how recent alumni are applying their skills, experience, and wisdom to life beyond campus.



Majors: Anthropology and Psychology
Minor: Asian American Studies
Fellowship Program: As a Coro Fellow, Zhu spent a year honing her leadership skills across diverse sectors, through rotating placements in government, nonprofit, labor, and business settings.
Her Haverford: As a passionate advocate for Asian communities, Zhu gained plenty of nonprofit experience during her time at Haverford. The Coro program seemed like “a great idea ... to gain exposure to other areas” as she prepares for future advocacy work on behalf of Asian students and immigrants. “As a daughter of Chinese working-class immigrants, I identify with those communities,” says Zhu. “So, for me...it’s important to give back and help others too.”
Major: Chemistry Minor: Religion
Fulbright Scholar: Mostaghim spent his time in Switzerland at the École Polytechnique Fédérale de Lausanne, where he was immersed in research within the field of nanobiotechnology and biosensor development. His Haverford: Mostaghim’s career aspirations are firmly rooted in his passion for both medicine and research. Karin Åkerfeldt, who taught Mostaghim organic chemistry, was instrumental in guiding him toward the Fulbright Scholarship. Her own experiences as a Fulbright Scholar from Sweden to the United States and her assistance with the application process were invaluable. His involvement in the Street Outreach Club at Haverford demonstrated the importance of teamwork and serving others, teaching him valuable life lessons regardless of his future career.
Majors: Computer Science and Mathematics
Job: Sharma is part of the Quantitative Research Team at Morning
His Haverford: Sharma actively engaged with the Center for Career and Professional Advising (CCPA), where he says he received invaluable guidance in exploring opportunities, networking, and enhancing his professional skills. Beyond academics, Sharma’s involvement in various student organizations, such as the Students’ Council and the Honor Council, and his role in supporting incoming first-year students through International Student Orientation (ISO), Horizons, and Customs, not only facilitated his personal growth but also honed his leadership skills, such as communication, decisionmaking, and problem-solving.


Major:
Minors: Global Asian Studies and Environmental Studies Fellowship Program: White accepted a position at the Alaska Fellows Program, an organization dedicated to attracting and retaining young professionals to The Last Frontier, and will assist with their Tech Deployment Track.
Her Haverford: White spent time abroad in Iceland, where she took an independent research course and created a project about art as a form of scientific communication. She also developed an art exhibit with paintings, zines, and photographs, which was on view in VCAM in fall 2022. Her experience participating in the Carbon Neutrality Task Force and working in the Haverford Customs program revealed her strengths and passions. From them, White recognized the power of her multidisciplinary interests, her creativity, and her desire to work on issues related to people and the environment.

Job: Page has settled into New York City, working as a markets analyst at JPMorgan Chase on equity derivatives.
Her Haverford: Page’s extracurricular experiences at Haverford played a significant role in shaping her future goals. As a student-athlete on the women’s soccer team, she thrived in a fast-paced environment and developed valuable teamwork skills that translate well into her current role. Her involvement as an Admission Office Fellow, a member of the Student Athletic Advisory Committee, and an Economics Teaching Assistant further nurtured her collaborative and team-oriented nature. “I knew that following my graduation from Haverford, I wanted to pursue a role that emphasized collaboration and teamwork,” she says. “And my position at JPMorgan provides me with this opportunity.”
Haverford College
The final bell is such a beautiful sound.
Founders Bell rings for all the special occasions on campus, including the most memorable one: Commencement. As a senior, you’ll have truly earned the right to leave your mark on the bell— a modern-day tradition.

Major: History
Minor: East Asian Languages and Cultures
Job: Heller is a Business Analyst at McKinsey & Company with future aspirations in private equity or even starting his own copmany.
His Haverford: A student-athlete on the men’s lacrosse team, Heller found mentorship and guidance from one of his teammates, Kyle Buseck ‘20, who now works in private equity. A senior when Heller was a freshman, “[Buseck] kind of showed me through how finance recruiting works, and was really helpful to me throughout the process–looking at my resumé, helping me prepare for interviews, things like that. And that’s something that I’ve put a lot of effort trying to pass onto sort of the kids below me,” says Heller. Heller’s involvement in the student investment portfolio and finance initiative as the president further shaped his plans.
Center for Career and Professional Advising (CCPA)
Haverford’s employer connections, alumni network, easy-toaccess resources, and hands-on guidance help our students and alumni discover and make their next moves. Whether you’re exploring potential careers or on a direct path to a job, a fellowship, or graduate, medical, or law school, you can tap into a huge array of support services all along the way.
The CCPA, in Stokes Hall, helps you explore and prepare for meaningful careers and postgraduate experiences such as graduate school and fellowships. With support from the CCPA, you can learn about your unique fit for various paths, hone your resume and cover letter skills, prepare for interviews, research career paths, connect with employers, and secure internships and post-graduate opportunities.
Employers and alumni from various fields eagerly share their experiences, stories, and insights with students. Connect with them through online resources such as Handshake and Haverford Connect, as well as recruiting events such as campus interviews, career fairs, career treks, coffee chats, and meet-ups.


3,279
180
CONNECTIONS WITH STUDENTS (SPRING 2022-23)
College-sponsored funded summer internships per year
Internships benefit Fords by encouraging them to explore different career paths, foster connections with employers, and reality test career choices. Most critically, internships— build skills and networks that propel students to postgraduation success.
The CCPA can support you in securing internships and research positions in various industries. Additionally, the College has numerous funding sources to help support students to take full advantage of summer experiences.


Here are other ways to connect, engage, and explore through the CCPA .
Graduate and Professional School Advising Receive support from CCPA on the application process, application timeline, and testing requirements to submit strong applications for graduate programs and dental, medical, or law school.
Fellowship Advising
Apply to research, teach abroad, or receive funding for graduate school.
Enhance your technical, analytical, presentation, and communication skills through CCPA’s online resources and workshops.
Handshake serves as the central online career hub for Haverford students. Apply for internships or jobs, share your resumes with employers, and sign up for on-campus interviews, career events, and appointments with career, fellowship, and graduate/professional school advisors. haverford.joinhandshake.com
Thousands of Haverford alumni are eager to help you make your next move. Through Haverford Connect, our alumni directory and professional networking platform, 3400+ alumni have volunteered to offer career support, advice, and guidance. Through the system, you can:
• Search alumni by career, help topic, or location
• Gain insights into industries of interest
• Find alumni who can support you in your career and professional development
15,000+
The Whitehead Internship Program encourages rising Haverford first-years, sophomores, juniors and seniors to engage in summer work related to entrepreneurship, small business, venture capital, or finance. Created in honor of John Whitehead ’43, former Chair of Goldman Sachs and Deputy Secretary of State, the program generously funds more than a dozen summer internships and helps to match students each year with internships. Applicants are also allowed to design or line up their internship if they so choose. Samanyu Kurra ‘24 interned with the Ben Franklin Technology Partners, where he learned about venture capital and impact investing by analyzing company financials, studying industry competition, and assessing portfolio companies against KPIs.


At Haverford, you really need to be open to being challenged and working to meet the challenge. It starts with the academics, and extends to the Honor Code— to how you interact with people and to how you imagine yourself as a leader and as a person of influence.
—Dr. Ted Love ’81
Cardiologist Dr. Ted Love’s drive to save lives, which spans the medical and business worlds, began at Haverford. The CEO at Global Blood Therapeutics, in San Francisco, says that it was Haverford’s blend of academics, expectations, and support that steered him to where he is today.
“Haverford taught me that I could accomplish much more than I thought I could just through simple perseverance, commitment, and dedication,” he says.
“That’s something I’ve continued to build on, and the foundation for that was established here.”

Leading Global Blood Therapeutics in its efforts to develop a treatment for sickle cell disease, a chronic blood disease that in the U.S. most commonly affects African Americans.
HAVERFORD’S LASTING IMPACT
“The
way I run companies and meetings, I
tend to
try to strive for consensus. A lot of effort goes into making sure all voices are heard.”
BORN 1959
HUNTSVILLE, ALABAMA
CLASS 1981
MAJOR
Biology
An investigation of muscle actin and myosin structures using negative staining with electron microscopy
1981–1985
Attended Yale University School of Medicine
1985–1992
Cardiologist at Massachusetts General Hospital
1992–1998
Senior VP of product development and regulatory affairs at Genentech, overseeing the creation of drugs like Rituxan, Herceptin, Xolair, TNKase, Raptiva, and Avastin
2001–2009
Chairman and CEO at Nuvelo, a $1 billion company
Executive VP of research and development and technical operations at Onyx Pharmaceuticals, playing a key role in initiating and completing several of Onyx’s first Phase 3 clinical trials
2014–PRESENT CEO at Global Blood Therapeutics
Board member at the healthcare companies Amicus Therapeutics and Cascadian Therapeutics
Haverford alumni take their talents to elite graduate schools, marquee employers, and far-flung locations across the world.
No matter the field, Haverford grads are always in high demand. Why?
Values shaped by the Honor Code—dignity, respect, and honesty—guide their actions toward others. Their consensus-style approach to decision-making helps them discern what matters and what doesn’t, leading them to resolve conflicts more quickly and move forward as ethical leaders. And their broad-based education teaches them how to apply lessons learned in one area of study to another.
The skills, wisdom, and disposition you develop through Haverford’s liberal arts lens can be applied to so many different fields and careers all over the planet. As a Ford, you’ll automatically stand out in the world, and be better able to inform, heal, and improve it.

Some of the places the Classes of 2022 and 2023 are living, working, and continuing their studies:
Carnegie Mellon University
Columbia University
Dartmouth College
Duke University
Harvard University
Icahn School of Medicine at Mt. Sinai
Northwestern University
Oxford University
Sidney Kimmel Medical College at Thomas Jefferson University
The George Washington University
University of California, Los Angeles
University of California, San Diego
University of Chicago
University of Michigan
University of Pennsylvania
Washington University
Amazon
American Museum of Natural History
AmeriCorps
Capital One
Children’s Hospital of Philadelphia
Citigroup
City of San Francisco
Compass Lexecon
Cravath, Swaine & Moore
Dana Farber Cancer Institute
Epic
Federal Reserve Bank of Philadelphia
Gerson Lehrman Group
Goldman Sachs
IBM Corporation
Atlanta, GA
Boston, MA
Chicago, IL
Greensboro, NC
Haverford, PA
Los Angeles, CA
Malvern, PA
New York, NY
Canada
England
France
Ireland
Luxembourg
J.P. Morgan Chase
Massachusetts
General Hospital
McKinsey & Company
Meta
Microsoft Corporation
Morgan Stanley
National Institutes of Health
Ogilvy
PwC
Quaker Voluntary Service
Teach for America
UBS
University of Pennsylvania
U.S. Department of Justice
Vanguard
Wistar Institute
Palo Alto, CA
Philadelphia, PA
San Francisco, CA
San Diego, CA
Seattle, WA
Verona, WI
Washington, D.C.
Scotland
Spain
Taiwan
Thailand




During back-to-back summer internships at Oracle, the junior and men’s basketball player has created innovative solutions for the tech giant’s cloud infrastructure team. Perry’s work has helped streamline the company’s services that quickly transcribe recordings of virtual lectures and meetings, automatically segmenting chapters and generating a table of contents for quick reference in the future. He was also a member of Oracle’s KIEV team in his second year.
Olugbeko interned with the Abolitionist Law Center’s probation and parole campaign. The internship was funded by the Center for Peace and Global Citizenship. During her internship, she witnessed up close the injustice of the criminal legal system. She saw a parade of defendants—mostly Black men, mostly with limited education, often dealing with addiction—threatened with a return to the life they are trying so hard to avoid.
As an American Song Archives Intern, Schefer worked remotely from his New York City home for the Tulsa, Oklahomabased archives. He created displays and public programming that helped open the cultural and musical history of the folk genre to a wider audience. The internship is supported by the Hurford Center for the Arts and Humanities and the Center for Peace and Global Citizenship.
Sponsored by the Koshland Integrated Natural Sciences Center, the environmental studies major interned at the Massachusetts Audubon Society. Korgen spent her time in the sandy areas surrounding the marshes of Wellfleet, Massachusetts, protecting the threatened species of diamondback terrapins that nest there. She explored everything from environmental law to botany, but in conservation—and particularly the hands-on field work it requires—she’s found her true passion.


Through summer internships, academic-year fellowships, and community-engaged learning opportunities, the Center for Peace and Global Citizenship (CPGC) offers students multiple ways to deepen their dedication to peace and social justice and make meaningful connections and contributions to our neighboring Philadelphia community.
Philadelphia Justice & Equity Fellowship (PJEF)
Sponsored by the Center for Peace and Global Citizenship, the PJEF offers paid, year-round internships with organizations tackling racism while building inclusivity and social justice. During the academic year, students receive work study compensation for participating in the program, which includes skill-building workshops, bi-weekly reflection groups, and other professional development opportunities. During the summer, students receive a stipend to work full time following an intensive, 5-day orientation.
Abolitionist Law Center
African Family Health Organization
Asian Arts Initiative
Caribbean Community in Philadelphia (CCP) Council on American-Islamic Relations (CAIR)
Equal Access Law
HIAS Pennsylvania
Human Rights Coalition
Kensington Corridor Trust
New Sanctuary Movement
Puentes de Salud

Here’s where three recent graduates headed after earning their diplomas.
Professor Sabloff’s linear algebra course really helped shape my logical reasoning and thinking. Linear algebra is used heavily in many of the systems engineering courses at the University of Pennsylvania.
The collective focus on fairness in computing in the CS department has helped me be more aware of so many different ways our algorithms and models can have disastrous systemic biases, and thus how we can be more conscious of our assumptions and approaches.
QILONG (MATTHEW) CHEN
Computer Science Major Class of 2022
The computer science major is working as a rotation software engineer at Apple, focusing on artificial intelligence and machine learning. hav.to/wthmc
ANTHONY WALKER
Physics Major Class of 2022
Walker is pursuing a master’s degree in systems engineering at the University of Pennsylvania, as part of Haverford’s Accelerated Master’s program. hav.to/wthaw

Living in Quaker House, with its focus on intentional community living, is definitely part of why I pursued QVS.
ALISSA VANDENBARK
Psychology Major; Spanish and Political Science Minors Class of 2022
As part of her Quaker Voluntary Service fellowship, the psychology major is working as a developmental staff member with MANNA, a Philadelphia nonprofit. hav.to/wthav
A 1999 Haverford graduate, Tamar Adler has led a life of cooking and writing that’s taken her from kitchens to mastheads, with stints at Alice Waters’ Chez Panisse and Harper’s Magazine. As she considered the role Haverford played in shaping her arc this far, she said, “I’m reminded that professors at Haverford took students’ intelligences seriously. I’m amazed, thinking back on my time there, at the degree to which we, as students, were granted intellectual parity with the people that taught us.”

“We came up with a concept for a book about street food and spent time in Thailand interviewing vendors. It didn’t turn into a cookbook, but that was the beginning of the idea of writing about food.”
HAVERFORD’S LASTING IMPACT
“I left Haverford with true confidence in the validity of my thought processes, the legitimacy of my arguments, and my capacity to articulate what I was thinking.”
MAJOR
Comparative Literature
En(trance)s:
Magical French Feminism
A synthetic performance in two acts
AFTER GRADUATION
1999–2000
Domestic policy intern/analyst, American Friends Service Committee, Washington, DC
JUNE 2000
Extended tour of Asia
2001–2004
Intern-turned-associate editor, Harper’s Magazine, New York City
2005–2007
Chef at Farm 255, Athens, Georgia
2007–2009
Cook at Chez Panisse, Berkeley, California, co-founding and directing the second meat CSA in the country, and leading Slow Food Berkeley
2009–2010
Wrote An Everlasting Meal: Cooking With Economy and Grace, Brooklyn
2011–2013
Taught cooking, gave talks, contributed to The New York Times Book Review and TheNewYorker.com
2013–PRESENT
Contributor, Vogue Magazine and New York Times Book Review; columnist, New York Times Magazine; author of Something Old, Something New
There are few places where students are given as much freedom, respect, and sense of themselves as substantial humans as they are at Haverford.
—Tamar Adler ’99

Haverford attracts some of the world’s brightest and most engaging college-bound students every year. Our primary criterion for admission is academic excellence.
We admit students who are able and interested in achieving at the highest levels of scholarship and service; who will engage deeply and substantively in the community; and who are intent on growing both intellectually and personally.
The admission process is conducted as a comprehensive review, where each applicant is treated personally and individually and a broad range of information is taken into account. We provide you with the opportunity to convey the broadest sense possible of who you are, what you have achieved during your secondary school experience, and how you will both contribute to and grow from a Haverford education.

1. Common, Coalition, or QuestBridge Application
2. Haverford Supplement
3. School Report with most recent transcript (including 1st quarter grades if applying ED)
4. School Profile and Counselor Report
5. Two Teacher Evaluations (English, Math, Science, Social Studies or Foreign Language)
6. $65 application fee or fee waiver
7. Required as soon as first trimester or first semester grades are available: Mid-Year School Report Form with attached Secondary School Transcript
8. Early Decision Form (for ED Applicants only)
Optional:
1. Standardized Test Results:
Either the SAT or ACT Exam. You can submit your self-reported or official scores in several ways. Learn more at: hav.to/howto
2. Supplemental material:
Arts (follow instructions on the Common Application website) or Athletics (please contact Haverford’s coach directly).
3. Interview:
While interviews are not required, we do recommend that all applicants interview. A virtual interview is a great way for us to get to know you better and another way for you to get to know Haverford.
For additional information regarding Early Decision, QuestBridge, and International Applicants, and for information on submitting optional supplemental material, visit hav.to/apply

Tuition: $67,520
Student activity fee: $498
Housing and food: $18,882
Total: $86,900
First-Year orientation fee: $280
$62,948
HAVERFORD GRANT AWARD
We are committed to making a Haverford education accessible and affordable.
With a $36 million annual aid budget, we meet the full demonstrated financial need of all admitted students –including international students, undocumented students, transfers, and students admitted from the waiting list. Nearly fifty percent of the student body receives some form of financial aid from Haverford.
We are equally committed to ensuring that all students thrive while at Haverford and have full access to the College’s educational and cultural opportunities, regardless of their financial resources. For example, your financial aid supports your participation in study abroad, social events on campus are free, and overall we strive to remove the hidden costs of attending college.
We are equally committed to minimizing student debt after graduation. If you’re a student from a family with an annual income below $60,000, you will not have any loans in your financial aid package; loan levels for incomes above that line range from only $1,500 to $3,000 per year.
The Haverford Student Loan Debt Relief Fund, an innovative program to help students who graduate from Haverford with debt, provides funds to young alumni who are in transition after graduation or who have jobs of high social value with low remuneration. This $2 million endowed fund is one of only a handful of such programs in the nation.





 Photo: Chris Mills ’82
Photo: Chris Mills ’82
